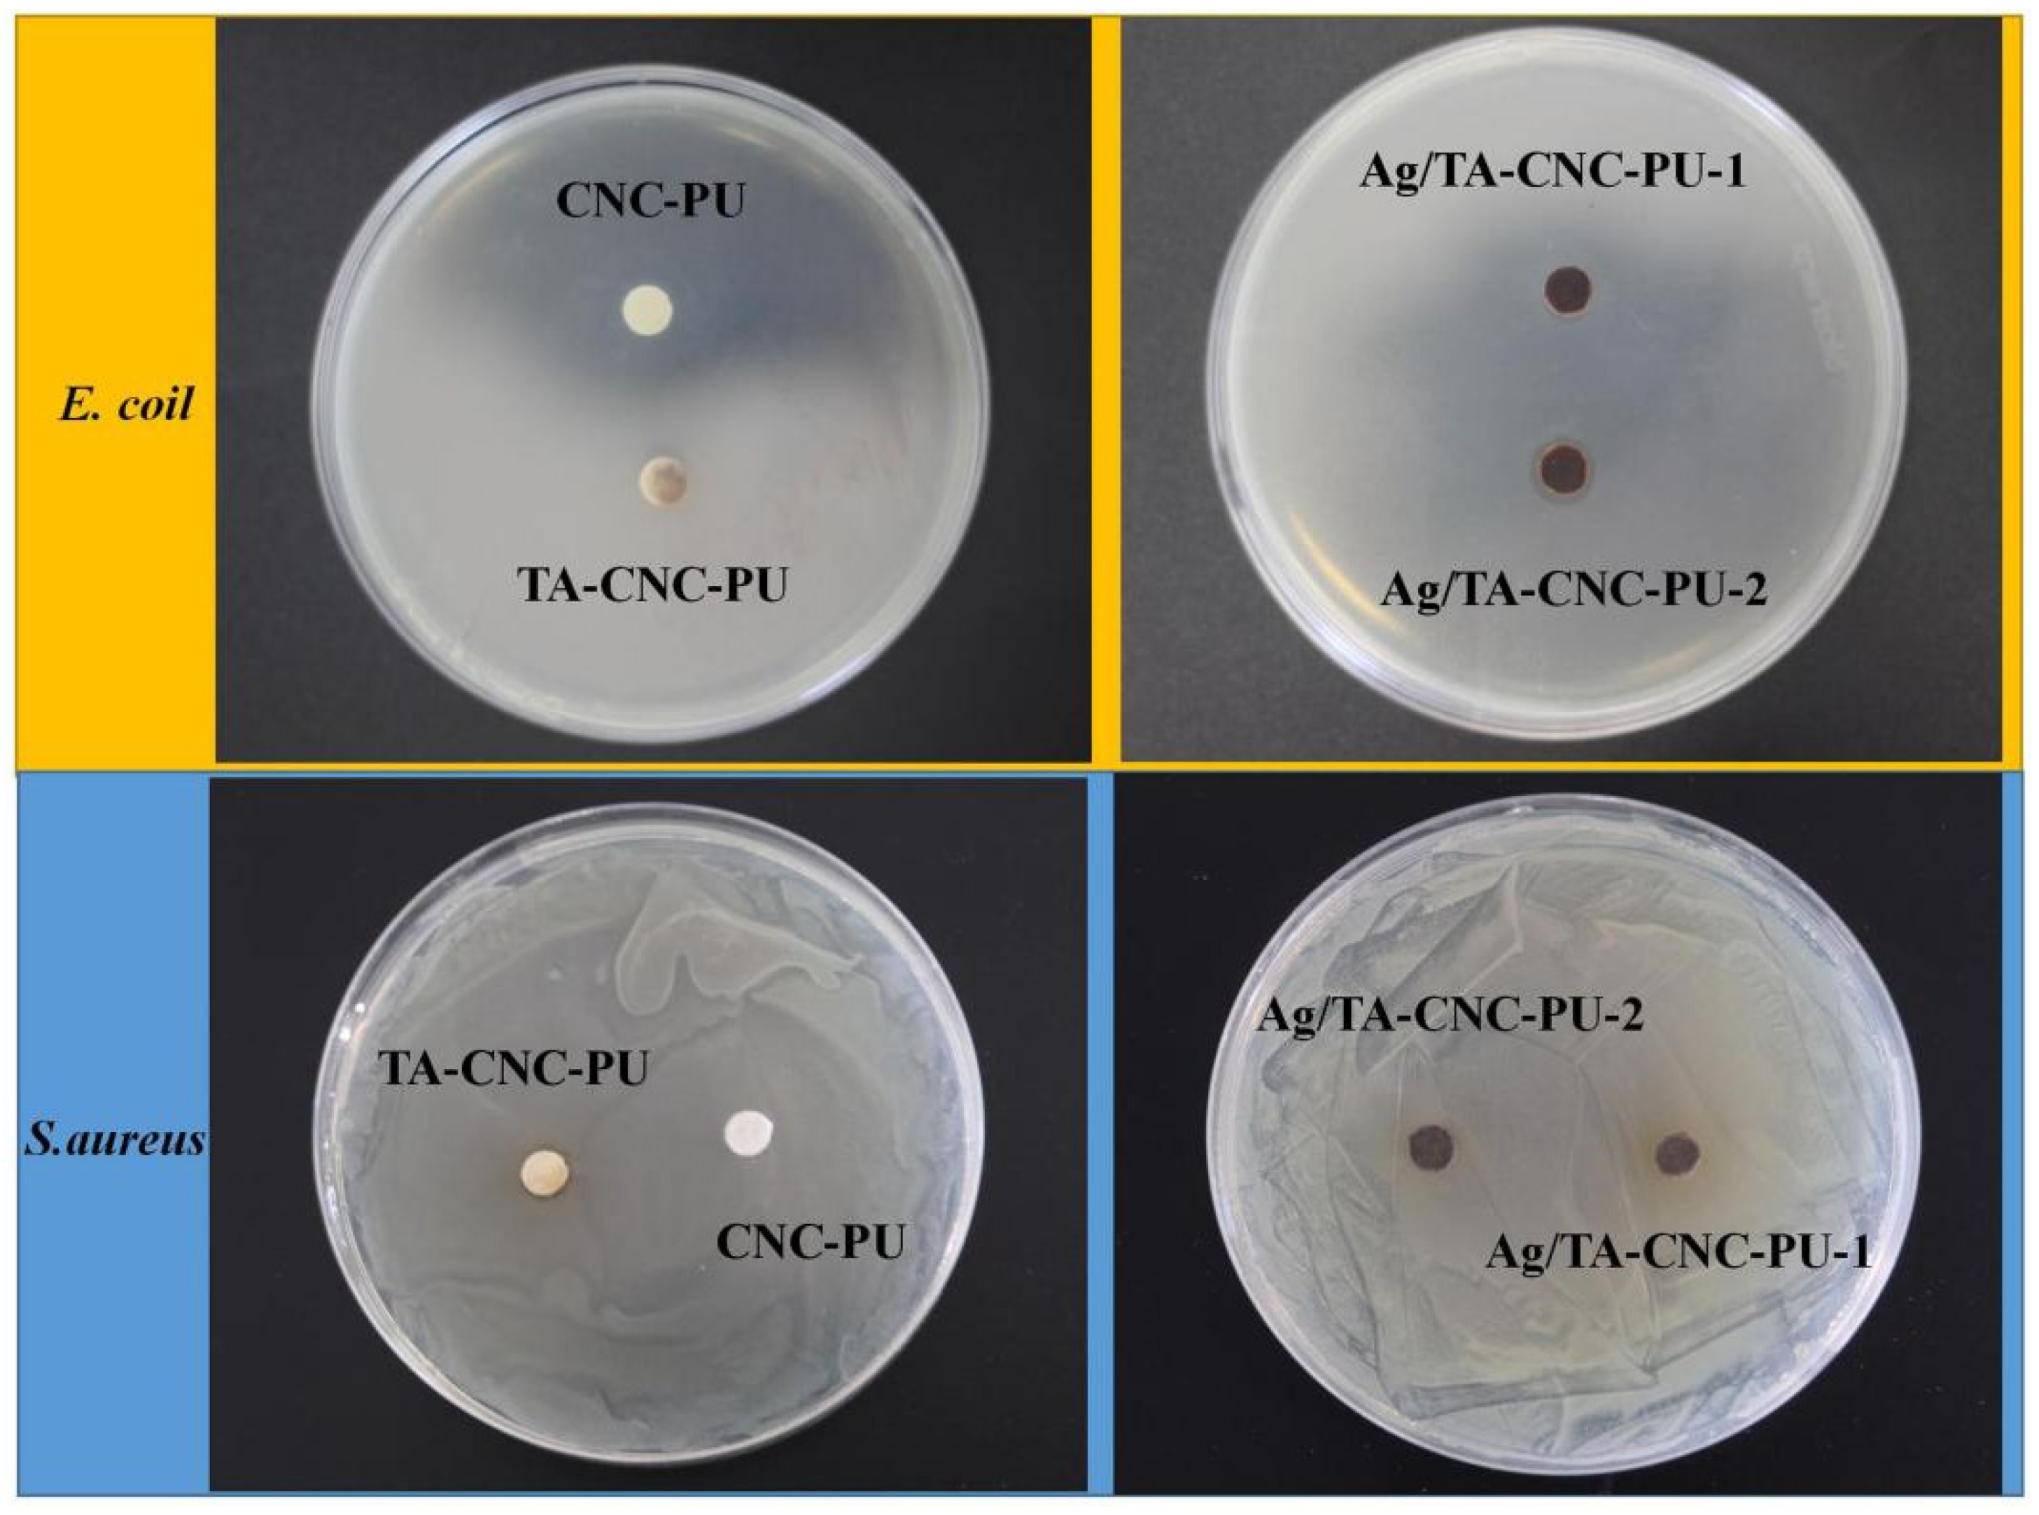
Polymers 14 02197 g007 550

Novel Cellulose Nanocrystals-Based Polyurethane: Synthesis, Characterization and Antibacterial Activity
Abstract
:1. Introduction
2. Materials and Methods
2.1. Materials
2.2. Synthesis of CNC-PU
2.3. Preparation of TA-CNC-PU
2.4. Synthesis of Ag/TA-CNC-PU
2.5. Structural Characterization
2.6. Thermal Analysis
2.7. Characterization of Hydrophilic and Hydrophobic Properties
2.8. Antibacterial Activity Tests
3. Results and Discussion
3.1. Structural Characteristics of CNCs-Based PUs
3.2. Thermal Analysis
3.3. Hydrophilic Properties
3.4. Antibacterial Activity
4. Conclusions
Author Contributions
Funding
Institutional Review Board Statement
Informed Consent Statement
Data Availability Statement
Conflicts of Interest
References
- Yao, Y.; Ding, J.; Wang, Z.; Zhang, H.; Xie, J.; Wang, Y.; Hong, L.; Mao, Z.; Gao, J.; Gao, C. ROS-responsive polyurethane fibrous patches loaded with methylprednisolone (MP) for restoring structures and functions of infarcted myocardium in vivo. Biomaterials 2020, 232, 119726. [Google Scholar] [CrossRef] [PubMed]
- Ma, Y.; Hu, N.; Liu, J.; Zhai, X.; Wu, M.; Hu, C.; Li, L.; Lai, Y.; Pan, H.; Lu, W.W.; et al. Three-dimensional printing of biodegradable piperazine-based polyurethane-urea scaffolds with enhanced osteogenesis for bone regeneration. ACS App. Mater. Interfaces 2019, 11, 9415–9424. [Google Scholar] [CrossRef] [PubMed]
- Tai, N.L.; Ghasemlou, M.; Adhikari, R.; Adhikari, B. Starch-based isocyanate- and non-isocyanate polyurethane hybrids: A review on synthesis, performance and biodegradation. Carbohydr. Polym. 2021, 265, 118029. [Google Scholar] [CrossRef] [PubMed]
- Manivannan, R.; Son, Y.A. A novel polymeric hybrid sensory smart material for the prompt recognition of mercury ions in water. Microchem. J. 2021, 170, 106707. [Google Scholar] [CrossRef]
- Herath, M.; Epaarachchi, J.; Islam, M.; Fang, L.; Leng, J. Light activated shape memory polymers and composites: A review. Eur. Polym. J. 2020, 136, 109912. [Google Scholar] [CrossRef]
- Kong, Y.; Santos-Carballal, D.; Martin, D.; Sergeeva, N.N.; Wang, W.; Liu, G.; Johnson, B.; Bhayana, B.; Lin, Z.; Wang, Y.; et al. A NIR-II-emitting gold nanocluster-based drug delivery system for smartphone-triggered photodynamic theranostics with rapid body clearance. Mater. Today 2021, 51, 96–107. [Google Scholar] [CrossRef]
- Kim, S.; Roe, D.G.; Choi, Y.Y.; Woo, H.; Park, J.; Lee, J.I.; Choi, Y.; Jo, S.B.; Kang, M.S.; Song, Y.J.; et al. Artificial stimulus-response system capable of conscious response. Sci. Adv. 2021, 7, 3996. [Google Scholar] [CrossRef]
- Huang, W.M.; Ding, Z.; Wang, C.C.; Wei, J.; Zhao, Y.; Purnawali, H. Shape memory materials. Mater. Today 2010, 13, 54–61. [Google Scholar] [CrossRef]
- Zhang, M.; Wang, H.; Mao, J.; Sun, D.; Liao, X. Intelligent deformation of biomedical polyurethane. Front. Mater. Sci. 2021, 15, 1–9. [Google Scholar] [CrossRef]
- Lugoloobi, I.; Maniriho, H.; Jia, L.; Namulinda, T.; Shi, X.; Zhao, Y. Cellulose nanocrystals in cancer diagnostics and treatment. J. Control. Release 2021, 336, 207–232. [Google Scholar] [CrossRef]
- Fan, Y.C.; Yue, Z.L.; Lucarelli, E.; Wallace, G.G.; Yue, Z.L.; Wallace, G.G. Hybrid printing using cellulose nanocrystals reinforced gelMA/HAMA hydrogels for improved structural integration. Adv. Healthc. Mater. 2020, 9, 2001410. [Google Scholar] [CrossRef] [PubMed]
- Jafari, S.; Nourany, M.; Zakizadeh, M.; Taghilou, A.; Ranjbar, H.A.; Noormohammadi, F. The effect of controlled phase separation of PEG/PCL-2000 homopolymer polyols using their PCL500-PEG1000-PCL500 tri-block copolymer and CNCs in the final polyurethane hydrogels on their shape memory behavior. Compos. Commun. 2020, 19, 194–202. [Google Scholar] [CrossRef]
- Saralegi, A.; Rueda, L.; Martin, L.; Arbelaiz, A.; Eceiza, A.; Corcuera, M.A. From elastomeric to rigid polyurethane/cellulose nanocrystal bionanocomposites. Compos. Sci. Technol. 2013, 88, 39−47. [Google Scholar] [CrossRef]
- Liu, Y.; Li, Y.; Yang, G.; Zheng, X.; Zhou, S. Multi-stimulus-responsive shape-memory polymer nanocomposite network cross-linked by cellulose nanocrystals. ACS App. Mater. Interfaces 2015, 7, 4118–4126. [Google Scholar] [CrossRef]
- Liu, J.C.; Martin, D.J.; Moon, R.J.; Youngblood, J.P. Enhanced thermal stability of biomedical thermoplastic polyurethane with the addition of cellulose nanocrystals. J. Appl. Polym. Sci. 2015, 132, 41970. [Google Scholar] [CrossRef]
- Girouard, N.M.; Xu, S.; Schueneman, G.T.; Shofner, M.L.; Meredith, J.C. Site-Selective Modifification of Cellulose Nanocrystals with Isophorone Diisocyanate and Formation of Polyurethane-CNC Composites. ACS Appl. Mater. Interfaces 2016, 8, 1458. [Google Scholar] [CrossRef]
- Mekonnen, T.H.; Haile, T.; Ly, M. Hydrophobic functionalization of cellulose nanocrystals for enhanced corrosion resistance of polyurethane nanocomposite coatings. ACS App. Mater. Interfaces 2021, 540, 148299. [Google Scholar] [CrossRef]
- Bae, S.H.; Lee, H.S.; Seo, S.G.; Kim, S.W.; Gwak, H.C.; Bae, S.Y. Debridement and functional rehabilitation for achilles tendon infection following tendon repair. J. Bone Joint Surg. 2016, 14, 1161–1167. [Google Scholar] [CrossRef]
- Arciola, C.R.; Campoccia, D.; Montanaro, L. Implant infections: Adhesion, biofilm formation and immune evasion. Nat. Rev. Microbiol. 2018, 16, 397–409. [Google Scholar] [CrossRef]
- Bing, W.; Cai, Y.; Jin, H.; Tian, L.; Tian, L.; Yin, Y.; Teng, Y.; Wang, P.; Hou, Z.; Bai, X. An antiadhesion and antibacterial platform based on parylene F coatings. Prog. Org. Coat. 2021, 151, 106021. [Google Scholar] [CrossRef]
- Singha, P.; Goudie, M.J.; Liu, Q.; Hopkins, S.; Brown, N.; Schmiedt, C.W.; Locklin, J.; Handa, H. Multipronged approach to combat catheter-associated infections and thrombosis by combining nitric oxide and a polyzwitterion: A 7 day in vivo study in a rabbit model. ACS App. Mater. Interfaces 2020, 12, 9070–9079. [Google Scholar] [CrossRef] [PubMed]
- Deng, J.R.; Zhao, C.L.; Wu, Y.X. Antibacterial and pH-responsive quaternized hydroxypropyl cellulose-g-poly(THF -co-epichlorohydrin) graft copolymer: Synthesis, characterization and properties. Chin. J. Polym. Sci. 2020, 38, 704–714. [Google Scholar] [CrossRef]
- Ge, L.; Li, Q.; Wang, M.; Ouyang, J.; Xing, M.M. Nanosilver particles in medical applications: Synthesis, performance, and toxicity. Int. J. Nanomed. 2014, 9, 2399–2407. [Google Scholar]
- He, X.; Gopinath, K.; Sathishkumar, G.; Guo, L.; Xu, L. UV-assisted deposition of antibacterial Ag-tannic acid nanocomposite coating. ACS App. Mater. Interfaces 2021, 13, 20708–20717. [Google Scholar] [CrossRef] [PubMed]
- Wang, X.; Wang, Z.; Fang, S.; Hou, Y.; Yuan, X. Injectable ag nanoclusters-based hydrogel for wound healing via eliminating bacterial infection and promoting tissue regeneration. Chem. Eng. J. 2021, 420, 127589. [Google Scholar] [CrossRef]
- Praveen; Suzuki, S.; Carsson, C.; Saunders, M.; Baker, M.V. Poly(2-hydroxyethyl methacrylate) sponges doped with Ag nanoparticles as antibacterial agents. ACS Appl. Nano Mater. 2020, 3, 1630–1639. [Google Scholar] [CrossRef]
- Furno, F.; Morley, K.S.; Wong, B.; Sharp, B.L.; Arnold, P.L.; Howdle, S.M.; Bayston, R.; Brown, P.D.; Winship, P.D.; Reid, H.J. Silver nanoparticles and polymeric medical devices: A new approach to prevention of infection? J. Antimicrob. Chemother. 2004, 54, 1019–1024. [Google Scholar] [CrossRef] [Green Version]
- Shi, H.; Liu, H.; Luan, S. Antibacterial and biocompatible properties of polyurethane nanofiber composites with integrated antifouling and bactericidal components. Compos. Sci. Technol. 2016, 127, 28–35. [Google Scholar] [CrossRef]
- Cheng, X.; Li, M.; Wang, H.; Cheng, Y. All-small-molecule dynamic covalent gels with antibacterial activity by boronate-tannic acid gelation. Chin. Chem. Lett. 2020, 31, 869–874. [Google Scholar] [CrossRef]
- Chen, Y.; Zhang, Y.; Mensaha, A.; Li, D.; Wei, Q. A plant-inspired long-lasting adhesive bilayer nanocomposite hydrogel based on redox-active Ag/tannic acid-cellulose nanofibers. Carbohydr. Polym. 2021, 255, 117508. [Google Scholar] [CrossRef]
- Zhang, M.; Wang, J.; Li, Y.; Lu, X.; Liao, X.; Zeng, G. Influence of soft segment molecular structure on physicochemical properties of cellulose nanocrystals based polyurethane. J. Phys. Conf. Ser. 2021, 2076, 012027. [Google Scholar] [CrossRef]
- Zhang, Z.; Sun, J.; Chen, X.; Wu, G.; Jin, Z.; Guo, D.; Liu, L. The synergistic effect of enhanced photocatalytic activity and photothermal effect of oxygen-deficient Ni/reduced graphene oxide nanocomposite for rapid disinfection under near-infrared irradiation. J. Hazard. Mater. 2021, 419, 126462. [Google Scholar] [CrossRef] [PubMed]
- Park, J.A.; Cho, K.Y.; Han, C.H.; Nam, A.; Kin, J.H.; Lee, S.H.; Choi, J.W. Quaternized Amphiphilic Block Copolymers/Graphene Oxide and a Poly(vinyl alcohol) Coating Layer on Graphene Oxide/Poly(vinylidene fluoride) Electrospun Nanofibers for Superhydrophilic and Antibacterial Properties. Sci. Rep. 2019, 9, 383. [Google Scholar] [CrossRef] [PubMed] [Green Version]
- Rueda, L.; Fernandez d’Arlas, B.; Zhou, Q.; Berglund, L.A.; Corcuera, M.A.; Mondragon, I.; Eceiza, A. Isocyanate-rich cellulose nanocrystals and their selective insertion in elastomeric polyurethane. Compos. Sci. Technol. 2011, 71, 1953–1960. [Google Scholar] [CrossRef]
- Rajar, K.; Soomro, R.A.; Ibupoto, Z.H.; Sirajuddin; Balouch, A. Tannic acid assisted copper oxide nanoglobules for sensitive electrochemical detection of bisphenol A. Int. J. Food Prop. 2017, 20, 1359−1367. [Google Scholar] [CrossRef]
- Khanjanzadeh, H.; Behrooz, R.; Bahramifar, N.; Gindl-Altmutter, W.; Bacher, M.; Edler, M.; Griesser, T. Surface chemical functionalization of cellulose nanocrystals by 3-aminopropyltriethoxysilane. Int. J. Biol. Macromol. 2018, 106, 1288–1296. [Google Scholar] [CrossRef] [PubMed]
- Habibi, Y.; Lucia, L.A.; Rojas, O.J. Cellulose nanocrystals: Chemistry, self-assembly, and applications. Chem. Rev. 2010, 110, 3479−3500. [Google Scholar] [CrossRef]
- Ly, M.; Mekonnen, T.H. Cationic surfactant modified cellulose nanocrystals for corrosion protective nanocomposite surface coatings. J. Ind. Eng. Chem. 2020, 83, 409–420. [Google Scholar] [CrossRef]
- Hu, Z.; Berry, R.M.; Pelton, R.H.; Cranston, E.D. One-Pot Water-Based Hydrophobic Surface Modification of Cellulose Nanocrystals Using Plant Polyphenols. ACS Sustain. Chem. Eng. 2017, 5, 5018–5026. [Google Scholar] [CrossRef]
- Sileika, T.S.; Barrett, D.G.; Zhang, R.; Lau, K.H.A.; Messersmith, P.B. Colorless Multifunctional Coatings Inspired by Polyphenols Found in Tea, Chocolate, and Wine. Angew. Chem. Int. Edit. 2013, 52, 10766–10770. [Google Scholar] [CrossRef] [Green Version]
- Mohammed, H.; Kumar, A.; Cazzola, M.; Salem, W.M.; Verné, E.; Spriano, S.; Rimondini, L. Surface Functionalization of Bioactive Glasses with Polyphenols from Padina pavonica Algae and In Situ Reduction of Silver Ions: Physico-Chemical Characterization and Biological Response. Coatings 2019, 9, 394. [Google Scholar]
- Kaczmarek, B. Tannic acid with antiviral and antibacterial activity as a promising component of biomaterials—A minireview. Materials 2020, 13, 3224. [Google Scholar] [CrossRef] [PubMed]
- Richter, M.F.; Hergenrother, P.J. The Challenge of Converting Gram-positive Only Compounds into Broad Spectrum Antibiotics. Ann. N. Y. Acad. Sci. 2019, 1435, 18–38. [Google Scholar] [CrossRef] [PubMed] [Green Version]
- Patil, M.P.; Seo, Y.B.; Kim, G.D. Morphological Changes of Bacterial Cells upon Exposure of Silver-silver Chloride Nanoparticles Synthesized Using Agrimonia Pilosa. Microb. Pathog. 2018, 116, 84–90. [Google Scholar] [CrossRef] [PubMed]
- Dong, G.; Liu, H.; Yu, X.; Zhang, X.; Lu, H.; Zhou, T.; Cao, J. Antimicrobial and anti-biofilm activity of tannic acid against Staphylococcus aureus. Nat. Prod. Res. 2018, 32, 2225–2228. [Google Scholar] [CrossRef] [PubMed]

Publisher’s Note: MDPI stays neutral with regard to jurisdictional claims in published maps and institutional affiliations. |
© 2022 by the authors. Licensee MDPI, Basel, Switzerland. This article is an open access article distributed under the terms and conditions of the Creative Commons Attribution (CC BY) license (https://creativecommons.org/licenses/by/4.0/).
Share and Cite
Zhang, M.; Lu, X.; Zhang, G.; Liao, X.; Wang, J.; Zhang, N.; Yu, C.; Zeng, G. Novel Cellulose Nanocrystals-Based Polyurethane: Synthesis, Characterization and Antibacterial Activity. Polymers 2022, 14, 2197. https://doi.org/10.3390/polym14112197
Zhang M, Lu X, Zhang G, Liao X, Wang J, Zhang N, Yu C, Zeng G. Novel Cellulose Nanocrystals-Based Polyurethane: Synthesis, Characterization and Antibacterial Activity. Polymers. 2022; 14(11):2197. https://doi.org/10.3390/polym14112197
Chicago/Turabian StyleZhang, Maolan, Xiujuan Lu, Guiping Zhang, Xiaoling Liao, Jiale Wang, Na Zhang, Chunyi Yu, and Guoming Zeng. 2022. "Novel Cellulose Nanocrystals-Based Polyurethane: Synthesis, Characterization and Antibacterial Activity" Polymers 14, no. 11: 2197. https://doi.org/10.3390/polym14112197
APA StyleZhang, M., Lu, X., Zhang, G., Liao, X., Wang, J., Zhang, N., Yu, C., & Zeng, G. (2022). Novel Cellulose Nanocrystals-Based Polyurethane: Synthesis, Characterization and Antibacterial Activity. Polymers, 14(11), 2197. https://doi.org/10.3390/polym14112197

